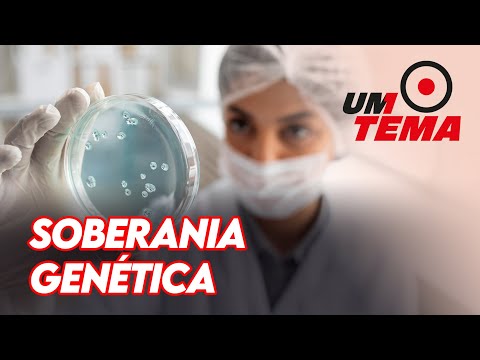

BUSCA AGROSOFT
Busca por palavra-chave = "unicamp" (mais recente para a mais antiga)1: TERMO SUPER EL NIÑO É ACEITO PELA CIÊNCIA?
 Publicado em 2026-05-22 05:48:28 por #Unicamp [540 hits]
Publicado em 2026-05-22 05:48:28 por #Unicamp [540 hits]
(A) Sim, totalmente aceito. (B) Apenas para eventos fracos. (C) Uso comum entre meteorologistas. (D) Não é considerado adequado.
Resposta: (D) Não é considerado adequado.
 Publicado em 2026-05-22 05:48:28 por #Unicamp [540 hits]
Publicado em 2026-05-22 05:48:28 por #Unicamp [540 hits](A) Sim, totalmente aceito. (B) Apenas para eventos fracos. (C) Uso comum entre meteorologistas. (D) Não é considerado adequado.
Resposta: (D) Não é considerado adequado.
2: IDADE APROXIMADA DOS FÓSSEIS DE PEIXES DO ARARIPE EXPOSTOS?
 Publicado em 2026-05-14 07:50:56 por #Unicamp [861 hits]
Publicado em 2026-05-14 07:50:56 por #Unicamp [861 hits]
(A) 50 milhões de anos. (B) Mais de 100 milhões de anos. (C) 10 mil anos. (D) 500 milhões de anos.
Resposta: (B) Mais de 100 milhões de anos.
 Publicado em 2026-05-14 07:50:56 por #Unicamp [861 hits]
Publicado em 2026-05-14 07:50:56 por #Unicamp [861 hits](A) 50 milhões de anos. (B) Mais de 100 milhões de anos. (C) 10 mil anos. (D) 500 milhões de anos.
Resposta: (B) Mais de 100 milhões de anos.
3: O QUE SÃO INFRAESTRUTURAS VERDES?
 Publicado em 2026-04-16 05:51:26 por #Unicamp [1122 hits]
Publicado em 2026-04-16 05:51:26 por #Unicamp [1122 hits]
(A) Concreto e asfalto. (B) Tubulações de esgoto. (C) Vegetação, solo e água integrados. (D) Pontes e viadutos.
Resposta: (C) Vegetação, solo e água integrados.
 Publicado em 2026-04-16 05:51:26 por #Unicamp [1122 hits]
Publicado em 2026-04-16 05:51:26 por #Unicamp [1122 hits](A) Concreto e asfalto. (B) Tubulações de esgoto. (C) Vegetação, solo e água integrados. (D) Pontes e viadutos.
Resposta: (C) Vegetação, solo e água integrados.
4: EM QUAL ARQUIPÉLAGO A BEGÔNIA CONSIDERADA EXTINTA FOI REDESCOBERTA?
 Publicado em 2026-04-10 09:52:50 por #Unicamp [754 hits]
Publicado em 2026-04-10 09:52:50 por #Unicamp [754 hits]
(A) Fernando de Noronha. (B) Alcatrazes (SP). (C) Ilhabela. (D) Abrolhos.
Resposta: (B) Alcatrazes (SP).
 Publicado em 2026-04-10 09:52:50 por #Unicamp [754 hits]
Publicado em 2026-04-10 09:52:50 por #Unicamp [754 hits](A) Fernando de Noronha. (B) Alcatrazes (SP). (C) Ilhabela. (D) Abrolhos.
Resposta: (B) Alcatrazes (SP).
5: QUAL GÁS É COGITADO PARA FUSÃO NUCLEAR E PODE SER EXTRAÍDO NA LUA?
 Publicado em 2026-04-08 12:48:16 por #Unicamp [1115 hits]
Publicado em 2026-04-08 12:48:16 por #Unicamp [1115 hits]
(A) Hélio-3. (B) Deutério. (C) Trítio. (D) Xenônio.
Resposta: (A) Hélio-3
 Publicado em 2026-04-08 12:48:16 por #Unicamp [1115 hits]
Publicado em 2026-04-08 12:48:16 por #Unicamp [1115 hits](A) Hélio-3. (B) Deutério. (C) Trítio. (D) Xenônio.
Resposta: (A) Hélio-3
6: QUAL EQUIPAMENTO DOADO É USADO PARA TAREFAS DE IA?
 Publicado em 2026-04-07 09:48:45 por #Unicamp [611 hits]
Publicado em 2026-04-07 09:48:45 por #Unicamp [611 hits]
(A) Roteadores. (B) TV boxes. (C) Monitores. (D) Cabos de rede.
Resposta: (B) TV boxes
 Publicado em 2026-04-07 09:48:45 por #Unicamp [611 hits]
Publicado em 2026-04-07 09:48:45 por #Unicamp [611 hits](A) Roteadores. (B) TV boxes. (C) Monitores. (D) Cabos de rede.
Resposta: (B) TV boxes
7: QUAL IDEIA CENTRAL ANA PRIMAVESI DEFENDIA SOBRE O SOLO?
 Publicado em 2026-04-02 05:50:15 por #Unicamp [961 hits]
Publicado em 2026-04-02 05:50:15 por #Unicamp [961 hits]
(A) Solo como suporte inerte para plantas. (B) Solo como organismo vivo com microrganismos. (C) Solo precisa de adubação química pesada. (D) Solo tropical igual ao europeu.
Resposta: (B) Solo como organismo vivo com microrganismos.
 Publicado em 2026-04-02 05:50:15 por #Unicamp [961 hits]
Publicado em 2026-04-02 05:50:15 por #Unicamp [961 hits](A) Solo como suporte inerte para plantas. (B) Solo como organismo vivo com microrganismos. (C) Solo precisa de adubação química pesada. (D) Solo tropical igual ao europeu.
Resposta: (B) Solo como organismo vivo com microrganismos.
8: QUAL PROGRAMA FEZ O BRASIL SAIR DO MAPA DA FOME PELA PRIMEIRA VEZ EM 2014?
 Publicado em 2026-03-26 05:50:41 por #Unicamp [789 hits]
Publicado em 2026-03-26 05:50:41 por #Unicamp [789 hits]
(A) Bolsa Família. (B) Fome Zero. (C) Brasil Sem Miséria. (D) Alimenta Brasil.
Resposta: (B) Fome Zero.
 Publicado em 2026-03-26 05:50:41 por #Unicamp [789 hits]
Publicado em 2026-03-26 05:50:41 por #Unicamp [789 hits](A) Bolsa Família. (B) Fome Zero. (C) Brasil Sem Miséria. (D) Alimenta Brasil.
Resposta: (B) Fome Zero.
9: O BRASIL ZEROU A TRANSMISSÃO VERTICAL DE QUE VÍRUS?
 Publicado em 2026-03-19 13:48:44 por #Unicamp [525 hits]
Publicado em 2026-03-19 13:48:44 por #Unicamp [525 hits]
(A) Zika. (B) HIV. (C) Hepatite C. (D) HPV.
Resposta: (B) HIV.
 Publicado em 2026-03-19 13:48:44 por #Unicamp [525 hits]
Publicado em 2026-03-19 13:48:44 por #Unicamp [525 hits](A) Zika. (B) HIV. (C) Hepatite C. (D) HPV.
Resposta: (B) HIV.
10: COMO FUNCIONA O ESTIMULADOR DE MEDULA ESPINHAL DO SUS?
 Publicado em 2026-03-05 07:52:14 por #Unicamp [301 hits]
Publicado em 2026-03-05 07:52:14 por #Unicamp [301 hits]
(A) Libera analgésicos na corrente sanguínea. (B) Bloqueia o sinal de dor antes do cérebro. (C) Massageia a região afetada. (D) Aquece os nervos para aliviar a dor.
Resposta: (B) Bloqueia o sinal de dor antes do cérebro.
 Publicado em 2026-03-05 07:52:14 por #Unicamp [301 hits]
Publicado em 2026-03-05 07:52:14 por #Unicamp [301 hits](A) Libera analgésicos na corrente sanguínea. (B) Bloqueia o sinal de dor antes do cérebro. (C) Massageia a região afetada. (D) Aquece os nervos para aliviar a dor.
Resposta: (B) Bloqueia o sinal de dor antes do cérebro.
11: PRINCIPAL FATOR POR TRÁS DO AUMENTO DE DESASTRES NATURAIS, SEGUNDO TEXTO:
 Publicado em 2026-03-03 11:54:07 por #Unicamp [317 hits]
Publicado em 2026-03-03 11:54:07 por #Unicamp [317 hits]
(A) lixo nas cidades. (B) aquecimento global. (C) marés de sizígia. (D) furacões no Pacífico.
Resposta: (B) aquecimento global
 Publicado em 2026-03-03 11:54:07 por #Unicamp [317 hits]
Publicado em 2026-03-03 11:54:07 por #Unicamp [317 hits](A) lixo nas cidades. (B) aquecimento global. (C) marés de sizígia. (D) furacões no Pacífico.
Resposta: (B) aquecimento global
12: ESTUDO DA UNICAMP APONTA QUE FIM DA ESCALA 6X1 PODE GERAR ATÉ:
 Publicado em 2026-03-03 06:51:52 por #TVCultura [312 hits]
Publicado em 2026-03-03 06:51:52 por #TVCultura [312 hits]
(A) 1,5 milhão de empregos. (B) 4,5 milhões de empregos. (C) 7 milhões de empregos. (D) 900 mil empregos.
Resposta: (B) 4,5 milhões de empregos
 Publicado em 2026-03-03 06:51:52 por #TVCultura [312 hits]
Publicado em 2026-03-03 06:51:52 por #TVCultura [312 hits](A) 1,5 milhão de empregos. (B) 4,5 milhões de empregos. (C) 7 milhões de empregos. (D) 900 mil empregos.
Resposta: (B) 4,5 milhões de empregos
13: QUAL A POTÊNCIA DA RESISTÊNCIA DO NOVO AQUECEDOR DA UNICAMP?
 Publicado em 2026-02-12 12:48:45 por #Unicamp [324 hits]
Publicado em 2026-02-12 12:48:45 por #Unicamp [324 hits]
(A) 50W. (B) 120W. (C) 500W. (D) 1200W.
Resposta: (B) 120W.
 Publicado em 2026-02-12 12:48:45 por #Unicamp [324 hits]
Publicado em 2026-02-12 12:48:45 por #Unicamp [324 hits](A) 50W. (B) 120W. (C) 500W. (D) 1200W.
Resposta: (B) 120W.
14: ONDE A PESQUISA IDENTIFICOU UMA NOVA ÁREA DE RISCO?
 Publicado em 2026-02-05 05:51:21 por #Unicamp [584 hits]
Publicado em 2026-02-05 05:51:21 por #Unicamp [584 hits]
(A) No sertão da Bahia. (B) No interior do Piauí. (C) Em uma área do Ceará. (D) No agreste pernambucano.
Resposta: (C) Em uma área do Ceará.
 Publicado em 2026-02-05 05:51:21 por #Unicamp [584 hits]
Publicado em 2026-02-05 05:51:21 por #Unicamp [584 hits](A) No sertão da Bahia. (B) No interior do Piauí. (C) Em uma área do Ceará. (D) No agreste pernambucano.
Resposta: (C) Em uma área do Ceará.
15: O QUE OS CIENTISTAS MANTIVERAM DESDE A INFÂNCIA?
 Publicado em 2026-02-03 14:49:34 por #Unicamp [441 hits]
Publicado em 2026-02-03 14:49:34 por #Unicamp [441 hits]
(A) Hábito de colecionar. (B) Prática de esportes. (C) Curiosidade e questionamento. (D) Interesse por literatura.
Resposta: (C) Curiosidade e questionamento.
 Publicado em 2026-02-03 14:49:34 por #Unicamp [441 hits]
Publicado em 2026-02-03 14:49:34 por #Unicamp [441 hits](A) Hábito de colecionar. (B) Prática de esportes. (C) Curiosidade e questionamento. (D) Interesse por literatura.
Resposta: (C) Curiosidade e questionamento.
16: O QUE AVALIA O EXAME NACIONAL DE AVALIAÇÃO DA FORMAÇÃO MÉDICA?
 Publicado em 2026-01-27 12:48:18 por #Unicamp [506 hits]
Publicado em 2026-01-27 12:48:18 por #Unicamp [506 hits]
(A) A infraestrutura dos hospitais escola. (B) O conhecimento dos estudantes no final do curso. (C) O currículo dos professores. (D) A duração do curso.
Resposta: (B) O conhecimento dos estudantes no final do curso.
 Publicado em 2026-01-27 12:48:18 por #Unicamp [506 hits]
Publicado em 2026-01-27 12:48:18 por #Unicamp [506 hits](A) A infraestrutura dos hospitais escola. (B) O conhecimento dos estudantes no final do curso. (C) O currículo dos professores. (D) A duração do curso.
Resposta: (B) O conhecimento dos estudantes no final do curso.
17: O QUE SÃO OS TECTITOS ENCONTRADOS NO BRASIL?
 Publicado em 2026-01-22 10:48:20 por #Unicamp [284 hits]
Publicado em 2026-01-22 10:48:20 por #Unicamp [284 hits]
(A) Minérios de ferro. (B) Vidros de impacto cósmico. (C) Fósseis de dinossauros. (D) Cristais de quartzo.
Resposta: (B) Vidros de impacto cósmico.
 Publicado em 2026-01-22 10:48:20 por #Unicamp [284 hits]
Publicado em 2026-01-22 10:48:20 por #Unicamp [284 hits](A) Minérios de ferro. (B) Vidros de impacto cósmico. (C) Fósseis de dinossauros. (D) Cristais de quartzo.
Resposta: (B) Vidros de impacto cósmico.
18: QUANTO MICROPLÁSTICO UMA PESSOA INGERE POR SEMANA?
 Publicado em 2026-01-19 20:48:23 por #Unicamp [310 hits]
Publicado em 2026-01-19 20:48:23 por #Unicamp [310 hits]
(A) 1 grama. (B) 5 gramas (um cartão de crédito). (C) 10 gramas. (D) 20 gramas.
Resposta: (B) 5 gramas (um cartão de crédito).
 Publicado em 2026-01-19 20:48:23 por #Unicamp [310 hits]
Publicado em 2026-01-19 20:48:23 por #Unicamp [310 hits](A) 1 grama. (B) 5 gramas (um cartão de crédito). (C) 10 gramas. (D) 20 gramas.
Resposta: (B) 5 gramas (um cartão de crédito).
19: O QUE O SONO PROFUNDO FAZ, SEGUNDO A MATÉRIA?
 Publicado em 2025-12-23 06:48:12 por #Unicamp [609 hits]
Publicado em 2025-12-23 06:48:12 por #Unicamp [609 hits]
(A) Aumenta a frequência cardíaca. (B) Consolida a memória e limpa o cérebro. (C) Reduz a temperatura corporal. (D) Estimula a digestão.
Resposta: (B) Consolida a memória e limpa o cérebro.
 Publicado em 2025-12-23 06:48:12 por #Unicamp [609 hits]
Publicado em 2025-12-23 06:48:12 por #Unicamp [609 hits](A) Aumenta a frequência cardíaca. (B) Consolida a memória e limpa o cérebro. (C) Reduz a temperatura corporal. (D) Estimula a digestão.
Resposta: (B) Consolida a memória e limpa o cérebro.
20: O QUE A MÁ QUALIDADE DO SONO PODE CAUSAR?
 Publicado em 2025-12-22 06:53:55 por #Unicamp [779 hits]
Publicado em 2025-12-22 06:53:55 por #Unicamp [779 hits]
(A) Aumento de apetite. (B) Morte precoce. (C) Melhora da memória. (D) Crescimento muscular.
Resposta: (B) Morte precoce.
 Publicado em 2025-12-22 06:53:55 por #Unicamp [779 hits]
Publicado em 2025-12-22 06:53:55 por #Unicamp [779 hits](A) Aumento de apetite. (B) Morte precoce. (C) Melhora da memória. (D) Crescimento muscular.
Resposta: (B) Morte precoce.
21: O QUE DESCOBRIRAM SOBRE FORMIGAS EM FIJI?
 Publicado em 2025-11-28 05:51:07 por #Unicamp [743 hits]
Publicado em 2025-11-28 05:51:07 por #Unicamp [743 hits]
(A) Aumentaram 80% em população. (B) 80% das espécies em declínio. (C) Desenvolveram resistência. (D) Migraram para outras ilhas.
Resposta: (B) 80% das espécies em declínio.
 Publicado em 2025-11-28 05:51:07 por #Unicamp [743 hits]
Publicado em 2025-11-28 05:51:07 por #Unicamp [743 hits](A) Aumentaram 80% em população. (B) 80% das espécies em declínio. (C) Desenvolveram resistência. (D) Migraram para outras ilhas.
Resposta: (B) 80% das espécies em declínio.
22: ONDE BALEIAS-AZUIS ENFRENTAM PROBLEMAS DE MOBILIDADE?
 Publicado em 2025-11-27 05:51:43 por #Unicamp [993 hits]
Publicado em 2025-11-27 05:51:43 por #Unicamp [993 hits]
(A) Golfo do México. (B) Golfo de Corcovado. (C) Mar Mediterrâneo. (D) Oceano Índico.
Resposta: (B) Golfo de Corcovado.
 Publicado em 2025-11-27 05:51:43 por #Unicamp [993 hits]
Publicado em 2025-11-27 05:51:43 por #Unicamp [993 hits](A) Golfo do México. (B) Golfo de Corcovado. (C) Mar Mediterrâneo. (D) Oceano Índico.
Resposta: (B) Golfo de Corcovado.
23: O QUE FOI REGISTRADO NO CANADÁ?
 Publicado em 2025-11-13 16:49:06 por #Unicamp [915 hits]
Publicado em 2025-11-13 16:49:06 por #Unicamp [915 hits]
(A) Movimentação de placas. (B) Erupção vulcânica. (C) Novo arquipélago. (D) Tsunami.
Resposta: (A) Movimentação de placas.
 Publicado em 2025-11-13 16:49:06 por #Unicamp [915 hits]
Publicado em 2025-11-13 16:49:06 por #Unicamp [915 hits](A) Movimentação de placas. (B) Erupção vulcânica. (C) Novo arquipélago. (D) Tsunami.
Resposta: (A) Movimentação de placas.
24: ONDE FORAM ENCONTRADOS ARTEFATOS DE 2,4 MILHÕES DE ANOS?
 Publicado em 2025-11-10 18:48:02 por #Unicamp [936 hits]
Publicado em 2025-11-10 18:48:02 por #Unicamp [936 hits]
(A) Vale do Rio Zarqa, Jordânia. (B) Vale do Nilo, Egito. (C) Vale do Rift, África. (D) Vale do Indo, Índia.
Resposta: (A) Vale do Rio Zarqa, Jordânia
 Publicado em 2025-11-10 18:48:02 por #Unicamp [936 hits]
Publicado em 2025-11-10 18:48:02 por #Unicamp [936 hits](A) Vale do Rio Zarqa, Jordânia. (B) Vale do Nilo, Egito. (C) Vale do Rift, África. (D) Vale do Indo, Índia.
Resposta: (A) Vale do Rio Zarqa, Jordânia
25: ONDE SENSORES QUÂNTICOS PODEM SER USADOS EM MEDICINA?
 Publicado em 2025-11-10 07:48:53 por #Unicamp [940 hits]
Publicado em 2025-11-10 07:48:53 por #Unicamp [940 hits]
(A) Diagnóstico de doenças. (B) Cirurgias robóticas. (C) Produção de medicamentos. (D) Terapia genética.
Resposta: (A) Diagnóstico de doenças
 Publicado em 2025-11-10 07:48:53 por #Unicamp [940 hits]
Publicado em 2025-11-10 07:48:53 por #Unicamp [940 hits](A) Diagnóstico de doenças. (B) Cirurgias robóticas. (C) Produção de medicamentos. (D) Terapia genética.
Resposta: (A) Diagnóstico de doenças
26: QUAL VANTAGEM DO FERTILIZANTE DE AÇÃO LENTA?
 Publicado em 2025-10-30 05:50:02 por #Unicamp [869 hits]
Publicado em 2025-10-30 05:50:02 por #Unicamp [869 hits]
(A) Custo mais baixo. (B) Maior eficiência na aplicação. (C) Cor mais atraente. (D) Cheiro agradável.
Resposta: (B) Maior eficiência na aplicação.
 Publicado em 2025-10-30 05:50:02 por #Unicamp [869 hits]
Publicado em 2025-10-30 05:50:02 por #Unicamp [869 hits](A) Custo mais baixo. (B) Maior eficiência na aplicação. (C) Cor mais atraente. (D) Cheiro agradável.
Resposta: (B) Maior eficiência na aplicação.
27: QUANTAS ESPÉCIES DE BORBOLETAS FORAM CATALOGADAS?
 Publicado em 2025-10-21 05:53:17 por #Unicamp [793 hits]
Publicado em 2025-10-21 05:53:17 por #Unicamp [793 hits]
(A) 506 espécies. (B) 606 espécies. (C) 706 espécies. (D) 806 espécies.
Resposta: (C) 706 espécies
 Publicado em 2025-10-21 05:53:17 por #Unicamp [793 hits]
Publicado em 2025-10-21 05:53:17 por #Unicamp [793 hits](A) 506 espécies. (B) 606 espécies. (C) 706 espécies. (D) 806 espécies.
Resposta: (C) 706 espécies
28: A REMOÇÃO DE MATÉRIA ORGÂNICA NO ESTUDO FOI SUPERIOR A?
 Publicado em 2025-10-10 06:50:50 por #Unicamp [721 hits]
Publicado em 2025-10-10 06:50:50 por #Unicamp [721 hits]
(A) 70%. (B) 80%. (C) 90%. (D) 95%.
Resposta: (C) 90%
 Publicado em 2025-10-10 06:50:50 por #Unicamp [721 hits]
Publicado em 2025-10-10 06:50:50 por #Unicamp [721 hits](A) 70%. (B) 80%. (C) 90%. (D) 95%.
Resposta: (C) 90%
29: QUEM DESENVOLVEU IA CONTRA FAKE NEWS?
 Publicado em 2025-10-09 06:51:18 por #Unicamp [976 hits]
Publicado em 2025-10-09 06:51:18 por #Unicamp [976 hits]
(A) USP. (B) Unicamp. (C) MIT. (D) Stanford.
Resposta: (B) Unicamp.
 Publicado em 2025-10-09 06:51:18 por #Unicamp [976 hits]
Publicado em 2025-10-09 06:51:18 por #Unicamp [976 hits](A) USP. (B) Unicamp. (C) MIT. (D) Stanford.
Resposta: (B) Unicamp.
30: QUEM É MAIS AFETADO PELA FIBROMIALGIA?
 Publicado em 2025-09-17 21:49:50 por #Unicamp [1161 hits]
Publicado em 2025-09-17 21:49:50 por #Unicamp [1161 hits]
(A) Homens. (B) Mulheres. (C) Crianças. (D) Idosos.
Resposta: (B) Mulheres.
 Publicado em 2025-09-17 21:49:50 por #Unicamp [1161 hits]
Publicado em 2025-09-17 21:49:50 por #Unicamp [1161 hits](A) Homens. (B) Mulheres. (C) Crianças. (D) Idosos.
Resposta: (B) Mulheres.
31: O QUE OS MANGUES INDICAM?
 Publicado em 2025-09-04 19:50:10 por #Unicamp [1145 hits]
Publicado em 2025-09-04 19:50:10 por #Unicamp [1145 hits]
(A) Qualidade do ar. (B) Saúde do meio ambiente. (C) Nível dos oceanos. (D) Biodiversidade terrestre.
Resposta: (B) Saúde do meio ambiente.
 Publicado em 2025-09-04 19:50:10 por #Unicamp [1145 hits]
Publicado em 2025-09-04 19:50:10 por #Unicamp [1145 hits](A) Qualidade do ar. (B) Saúde do meio ambiente. (C) Nível dos oceanos. (D) Biodiversidade terrestre.
Resposta: (B) Saúde do meio ambiente.
32: DE ONDE VEM A MAIORIA DOS ANTIBIÓTICOS?
 Publicado em 2025-08-26 18:50:15 por #Unicamp [859 hits]
Publicado em 2025-08-26 18:50:15 por #Unicamp [859 hits]
(A) Plantas. (B) Animais. (C) Minerais. (D) Microrganismos.
Resposta: (D) Microrganismos.
Publicado em 2025-08-26 18:50:15 por #Unicamp [859 hits]
Publicado em 2025-08-26 18:50:15 por #Unicamp [859 hits](A) Plantas. (B) Animais. (C) Minerais. (D) Microrganismos.
Resposta: (D) Microrganismos.
33: QUE TECNOLOGIA LÊ LIVROS PARA CEGOS?
 Publicado em 2025-08-12 07:45:24 por #Unicamp [893 hits]
Publicado em 2025-08-12 07:45:24 por #Unicamp [893 hits]
(A) Scanner vocal. (B) Audiobook. (C) Inteligência artificial. (D) Aplicativo.
Resposta: (A) Scanner vocal.
 Publicado em 2025-08-12 07:45:24 por #Unicamp [893 hits]
Publicado em 2025-08-12 07:45:24 por #Unicamp [893 hits](A) Scanner vocal. (B) Audiobook. (C) Inteligência artificial. (D) Aplicativo.
Resposta: (A) Scanner vocal.
34: O QUE A COMPUTAÇÃO CRIATIVA TRANSFORMA EM EXPERIÊNCIAS SENSORIAIS?
 Publicado em 2025-08-08 05:45:49 por #Unicamp [1122 hits]
Publicado em 2025-08-08 05:45:49 por #Unicamp [1122 hits]
(A) Dados climáticos. (B) Redes sociais. (C) Notícias online. (D) Músicas populares.
Resposta: (A) Dados climáticos.
 Publicado em 2025-08-08 05:45:49 por #Unicamp [1122 hits]
Publicado em 2025-08-08 05:45:49 por #Unicamp [1122 hits](A) Dados climáticos. (B) Redes sociais. (C) Notícias online. (D) Músicas populares.
Resposta: (A) Dados climáticos.
35: COMO SE CHAMA A MOEDA DIGITAL BRASILEIRA?
 Publicado em 2025-08-07 16:45:24 por #Unicamp [957 hits]
Publicado em 2025-08-07 16:45:24 por #Unicamp [957 hits]
(A) Bitreal. (B) Drex. (C) Cryptoreal. (D) Pixcoin.
Resposta: (B) Drex.
 Publicado em 2025-08-07 16:45:24 por #Unicamp [957 hits]
Publicado em 2025-08-07 16:45:24 por #Unicamp [957 hits](A) Bitreal. (B) Drex. (C) Cryptoreal. (D) Pixcoin.
Resposta: (B) Drex.
36: QUAL ANIMAL TINHA RELAÇÃO SIMBIÓTICA COM O GAVIÃO-CARRAPATEIRO?
 Publicado em 2025-08-06 05:46:43 por #Unicamp [872 hits]
Publicado em 2025-08-06 05:46:43 por #Unicamp [872 hits]
(A) Capivaras. (B) Pássaros. (C) Peixes. (D) Insetos.
Resposta: (A) Capivaras.
 Publicado em 2025-08-06 05:46:43 por #Unicamp [872 hits]
Publicado em 2025-08-06 05:46:43 por #Unicamp [872 hits](A) Capivaras. (B) Pássaros. (C) Peixes. (D) Insetos.
Resposta: (A) Capivaras.
37: QUAL INDICADOR DEFINE SAÍDA DO MAPA DA FOME?
 Publicado em 2025-07-31 18:45:31 por #Unicamp [938 hits]
Publicado em 2025-07-31 18:45:31 por #Unicamp [938 hits]
(A) Menos de 2,5% subnutrição. (B) Aumento produção alimentos. (C) Redução preços. (D) Aumento PIB agrícola.
Resposta: (A) Menos de 2,5% subnutrição.
 Publicado em 2025-07-31 18:45:31 por #Unicamp [938 hits]
Publicado em 2025-07-31 18:45:31 por #Unicamp [938 hits](A) Menos de 2,5% subnutrição. (B) Aumento produção alimentos. (C) Redução preços. (D) Aumento PIB agrícola.
Resposta: (A) Menos de 2,5% subnutrição.
38: COMO DEVE SER A CIÊNCIA?
 Publicado em 2025-07-29 11:47:27 por #Unicamp [871 hits]
Publicado em 2025-07-29 11:47:27 por #Unicamp [871 hits]
(A) Exclusiva. (B) Acessível. (C) Tecnológica. (D) Restrita.
Resposta: (B) Acessível.
 Publicado em 2025-07-29 11:47:27 por #Unicamp [871 hits]
Publicado em 2025-07-29 11:47:27 por #Unicamp [871 hits](A) Exclusiva. (B) Acessível. (C) Tecnológica. (D) Restrita.
Resposta: (B) Acessível.
39: O QUE O ESTUDO DAS ABELHAS SEM FERRÃO INVESTIGA?
 Publicado em 2025-07-28 05:45:36 por #Unicamp [957 hits]
Publicado em 2025-07-28 05:45:36 por #Unicamp [957 hits]
(A) Potencial farmacológico dos compostos. (B) Hábitos de migração. (C) Técnicas de apicultura. (D) Efeitos do aquecimento.
Resposta: (A) Potencial farmacológico dos compostos
 Publicado em 2025-07-28 05:45:36 por #Unicamp [957 hits]
Publicado em 2025-07-28 05:45:36 por #Unicamp [957 hits](A) Potencial farmacológico dos compostos. (B) Hábitos de migração. (C) Técnicas de apicultura. (D) Efeitos do aquecimento.
Resposta: (A) Potencial farmacológico dos compostos
40: ONDE FOI DESENVOLVIDA A VACINA CONTRA ZIKA?
 Publicado em 2025-07-16 12:48:59 por #JovemPan [1105 hits]
Publicado em 2025-07-16 12:48:59 por #JovemPan [1105 hits]
(A) USP. (B) Unicamp. (C) Fiocruz. (D) Butantan.
Resposta: (A) USP.
 Publicado em 2025-07-16 12:48:59 por #JovemPan [1105 hits]
Publicado em 2025-07-16 12:48:59 por #JovemPan [1105 hits](A) USP. (B) Unicamp. (C) Fiocruz. (D) Butantan.
Resposta: (A) USP.
41: AGROTÓXICOS SÃO ENCONTRADOS NA CHUVA EM SÃO PAULO
 Publicado em 2025-07-13 18:45:36 por #TVCultura [1040 hits]
Publicado em 2025-07-13 18:45:36 por #TVCultura [1040 hits]
Pesquisadores da Universidade Estadual de Campinas, a Unicamp, detectaram a presença de 19 substâncias químicas na água da chuva de três cidades paulistas: Brotas, Campinas e São Paulo. O estudo, publicado em uma revista científica internacional, analisou 19 compostos usados no cultivo da cana-de-açúcar. O material, coletado entre 2019 e 2021, revelou a presença do agrotóxico carbendazim em 88% das amostras. O uso do produto está proibido pela Anvisa desde agosto de 2022 por apresentar potencial cancerígeno. Já a trasina, também considerada tóxica, mas de uso liberado, foi encontrada em 100% das coletas. É uma contaminação que ela não fica mais localizada e ela acaba sendo distribuída para outras regiões e atingindo a população de formas que a gente não esperaria estar expostos. Segundo os pesquisadores, as quantidades de agrotóxicos encontradas na chuva não apresentam risco significativo à saúde humana. Mas o problema é que essas substâncias estão também em outros lugares, na água das torneiras, nos alimentos e até no ar. Essas quantidades que nós estamos verificando eh na água de chuva, apesar de serem inferiores à aquelas que podem provocar dano ao ser humano, a somação delas pode trazer danos ao ser humano, particularmente no que diz respeito ao câncer. Por isso, a importância da regulação, da fiscalização do uso dos agrotóxicos, que é a responsabilidade do Ministério da Agricultura e também da Anvisa. Repensar um modelo agrícola cada vez mais sustentável, vai beneficiar não só o agro como um todo, mas a saúde do meio ambiente e, consequentemente, da população.
 Publicado em 2025-07-13 18:45:36 por #TVCultura [1040 hits]
Publicado em 2025-07-13 18:45:36 por #TVCultura [1040 hits]Pesquisadores da Universidade Estadual de Campinas, a Unicamp, detectaram a presença de 19 substâncias químicas na água da chuva de três cidades paulistas: Brotas, Campinas e São Paulo. O estudo, publicado em uma revista científica internacional, analisou 19 compostos usados no cultivo da cana-de-açúcar. O material, coletado entre 2019 e 2021, revelou a presença do agrotóxico carbendazim em 88% das amostras. O uso do produto está proibido pela Anvisa desde agosto de 2022 por apresentar potencial cancerígeno. Já a trasina, também considerada tóxica, mas de uso liberado, foi encontrada em 100% das coletas. É uma contaminação que ela não fica mais localizada e ela acaba sendo distribuída para outras regiões e atingindo a população de formas que a gente não esperaria estar expostos. Segundo os pesquisadores, as quantidades de agrotóxicos encontradas na chuva não apresentam risco significativo à saúde humana. Mas o problema é que essas substâncias estão também em outros lugares, na água das torneiras, nos alimentos e até no ar. Essas quantidades que nós estamos verificando eh na água de chuva, apesar de serem inferiores à aquelas que podem provocar dano ao ser humano, a somação delas pode trazer danos ao ser humano, particularmente no que diz respeito ao câncer. Por isso, a importância da regulação, da fiscalização do uso dos agrotóxicos, que é a responsabilidade do Ministério da Agricultura e também da Anvisa. Repensar um modelo agrícola cada vez mais sustentável, vai beneficiar não só o agro como um todo, mas a saúde do meio ambiente e, consequentemente, da população.
42: QUAL DOENÇA INTESTINAL ESTÁ AUMENTANDO?
 Publicado em 2025-07-10 19:46:59 por #Unicamp [967 hits]
Publicado em 2025-07-10 19:46:59 por #Unicamp [967 hits]
(A) Doença de Crohn. (B) Colite. (C) Síndrome do intestino irritável. (D) Diverticulite.
Resposta: (A) Doença de Crohn.
 Publicado em 2025-07-10 19:46:59 por #Unicamp [967 hits]
Publicado em 2025-07-10 19:46:59 por #Unicamp [967 hits](A) Doença de Crohn. (B) Colite. (C) Síndrome do intestino irritável. (D) Diverticulite.
Resposta: (A) Doença de Crohn.
43: O QUE É "PONTO DE NÃO RETORNO"?
 Publicado em 2025-07-09 18:45:41 por #Unicamp [941 hits]
Publicado em 2025-07-09 18:45:41 por #Unicamp [941 hits]
(A) Momento sem regeneração. (B) Início da recuperação. (C) Pico de poluição. (D) Fim dos recursos.
Resposta: (A) Momento sem regeneração.
 Publicado em 2025-07-09 18:45:41 por #Unicamp [941 hits]
Publicado em 2025-07-09 18:45:41 por #Unicamp [941 hits](A) Momento sem regeneração. (B) Início da recuperação. (C) Pico de poluição. (D) Fim dos recursos.
Resposta: (A) Momento sem regeneração.
44: ONDE FOI ENCONTRADO O FÓSSIL DE TARTARUGA?
 Publicado em 2025-07-03 12:48:27 por #Unicamp [1097 hits]
Publicado em 2025-07-03 12:48:27 por #Unicamp [1097 hits]
(A) Saara. (B) Amazônia. (C) Patagônia. (D) África.
Resposta: (B) Amazônia.
 Publicado em 2025-07-03 12:48:27 por #Unicamp [1097 hits]
Publicado em 2025-07-03 12:48:27 por #Unicamp [1097 hits](A) Saara. (B) Amazônia. (C) Patagônia. (D) África.
Resposta: (B) Amazônia.
45: QUAL PAÍS DO ORIENTE MÉDIO TEM ARMAS NUCLEARES?
 Publicado em 2025-07-03 10:45:15 por #Unicamp [1096 hits]
Publicado em 2025-07-03 10:45:15 por #Unicamp [1096 hits]
(A) Irã. (B) Israel. (C) Arábia Saudita. (D) Egito.
Resposta: (B) Israel.
 Publicado em 2025-07-03 10:45:15 por #Unicamp [1096 hits]
Publicado em 2025-07-03 10:45:15 por #Unicamp [1096 hits](A) Irã. (B) Israel. (C) Arábia Saudita. (D) Egito.
Resposta: (B) Israel.
46: O QUE PODE SER ADICIONADO AO AZEITE FALSIFICADO?
 Publicado em 2025-06-20 06:45:14 por #Unicamp [1182 hits]
Publicado em 2025-06-20 06:45:14 por #Unicamp [1182 hits]
(A) Óleo de soja. (B) Corantes. (C) Aromatizantes. (D) Todos acima.
Resposta: (D) Todos acima
 Publicado em 2025-06-20 06:45:14 por #Unicamp [1182 hits]
Publicado em 2025-06-20 06:45:14 por #Unicamp [1182 hits](A) Óleo de soja. (B) Corantes. (C) Aromatizantes. (D) Todos acima.
Resposta: (D) Todos acima
47: QUAL O OBJETIVO DA PARCERIA ENTRE UNICAMP E PETROBRAS?
 Publicado em 2025-06-19 06:50:04 por #CNN [1130 hits]
Publicado em 2025-06-19 06:50:04 por #CNN [1130 hits]
(A) Construir usinas nucleares. (B) Criar startups de alta tecnologia. (C) Explorar petróleo no pré-sal. (D) Formar técnicos em petróleo.
Resposta: (B) Criar startups de alta tecnologia.
 Publicado em 2025-06-19 06:50:04 por #CNN [1130 hits]
Publicado em 2025-06-19 06:50:04 por #CNN [1130 hits](A) Construir usinas nucleares. (B) Criar startups de alta tecnologia. (C) Explorar petróleo no pré-sal. (D) Formar técnicos em petróleo.
Resposta: (B) Criar startups de alta tecnologia.
48: O QUE É DINAPENIA?
 Publicado em 2025-06-18 21:45:34 por #Unicamp [965 hits]
Publicado em 2025-06-18 21:45:34 por #Unicamp [965 hits]
(A) Perda de memória. (B) Perda de força. (C) Obesidade. (D) Alergia.
Resposta: (B) Perda de força.
 Publicado em 2025-06-18 21:45:34 por #Unicamp [965 hits]
Publicado em 2025-06-18 21:45:34 por #Unicamp [965 hits](A) Perda de memória. (B) Perda de força. (C) Obesidade. (D) Alergia.
Resposta: (B) Perda de força.
49: O QUE GERA CONFLITOS NO ATO DE COMER?
 Publicado em 2025-06-17 18:46:07 por #Unicamp [965 hits]
Publicado em 2025-06-17 18:46:07 por #Unicamp [965 hits]
(A) Pressão pelo corpo perfeito. (B) Falta de alimentos. (C) Horários. (D) Preços.
Resposta: (A) Pressão pelo corpo perfeito.
 Publicado em 2025-06-17 18:46:07 por #Unicamp [965 hits]
Publicado em 2025-06-17 18:46:07 por #Unicamp [965 hits](A) Pressão pelo corpo perfeito. (B) Falta de alimentos. (C) Horários. (D) Preços.
Resposta: (A) Pressão pelo corpo perfeito.
50: QUAL CAFÉ TEM MAIS CAFEÍNA?
 Publicado em 2025-06-06 18:45:24 por #Unicamp [1066 hits]
Publicado em 2025-06-06 18:45:24 por #Unicamp [1066 hits]
(A) Arábica. (B) Robusta. (C) Iguais. (D) Nenhum.
Resposta: (B) Robusta.
 Publicado em 2025-06-06 18:45:24 por #Unicamp [1066 hits]
Publicado em 2025-06-06 18:45:24 por #Unicamp [1066 hits](A) Arábica. (B) Robusta. (C) Iguais. (D) Nenhum.
Resposta: (B) Robusta.
51: O QUE AUMENTA O COLESTEROL RUIM?
 Publicado em 2025-06-02 18:45:42 por #Unicamp [990 hits]
Publicado em 2025-06-02 18:45:42 por #Unicamp [990 hits]
(A) Gorduras insaturadas. (B) Gorduras saturadas. (C) Proteínas. (D) Carboidratos.
Resposta: (B) Gorduras saturadas.
 Publicado em 2025-06-02 18:45:42 por #Unicamp [990 hits]
Publicado em 2025-06-02 18:45:42 por #Unicamp [990 hits](A) Gorduras insaturadas. (B) Gorduras saturadas. (C) Proteínas. (D) Carboidratos.
Resposta: (B) Gorduras saturadas.
52: PARA QUE SERVE O GUACO?
 Publicado em 2025-05-30 19:45:39 por #Unicamp [1033 hits]
Publicado em 2025-05-30 19:45:39 por #Unicamp [1033 hits]
(A) Digestão. (B) Respiração. (C) Dor. (D) Febre.
Resposta: (B) Respiração.
 Publicado em 2025-05-30 19:45:39 por #Unicamp [1033 hits]
Publicado em 2025-05-30 19:45:39 por #Unicamp [1033 hits](A) Digestão. (B) Respiração. (C) Dor. (D) Febre.
Resposta: (B) Respiração.
53: COMO HUMANOS PODEM SE INFECTAR DE GRIPE AVIÁRIA?
 Publicado em 2025-05-26 22:47:45 por #Unicamp [941 hits]
Publicado em 2025-05-26 22:47:45 por #Unicamp [941 hits]
(A) Comendo frango. (B) Contato direto. (C) Ar contaminado. (D) Água contaminada.
Resposta: (B) Contato direto.
 Publicado em 2025-05-26 22:47:45 por #Unicamp [941 hits]
Publicado em 2025-05-26 22:47:45 por #Unicamp [941 hits](A) Comendo frango. (B) Contato direto. (C) Ar contaminado. (D) Água contaminada.
Resposta: (B) Contato direto.
54: O QUE DEFINE UM ALIMENTO ULTRAPROCESSADO?
 Publicado em 2025-05-16 12:45:36 por #Unicamp [1090 hits]
Publicado em 2025-05-16 12:45:36 por #Unicamp [1090 hits]
(A) Muitos ingredientes. (B) Cor artificial. (C) Embalagem plástica. (D) Preço alto.
Resposta: (A) Muitos ingredientes.
 Publicado em 2025-05-16 12:45:36 por #Unicamp [1090 hits]
Publicado em 2025-05-16 12:45:36 por #Unicamp [1090 hits](A) Muitos ingredientes. (B) Cor artificial. (C) Embalagem plástica. (D) Preço alto.
Resposta: (A) Muitos ingredientes.
55: COMO DEVE SER VISTA A RESTRIÇÃO ALIMENTAR?
 Publicado em 2025-05-13 07:45:41 por #Unicamp [974 hits]
Publicado em 2025-05-13 07:45:41 por #Unicamp [974 hits]
(A) Como regra. (B) Como exceção. (C) Como obrigação. (D) Como moda.
Resposta: (B) Como exceção.
 Publicado em 2025-05-13 07:45:41 por #Unicamp [974 hits]
Publicado em 2025-05-13 07:45:41 por #Unicamp [974 hits](A) Como regra. (B) Como exceção. (C) Como obrigação. (D) Como moda.
Resposta: (B) Como exceção.
56: ALÉM DE RIQUEZA, ONDE O OURO TAMBÉM É UTILIZADO?
 Publicado em 2025-04-30 16:45:17 por #Unicamp [1052 hits]
Publicado em 2025-04-30 16:45:17 por #Unicamp [1052 hits]
(A) Tecnologia. (B) Alimentação. (C) Vestuário. (D) Transporte.
Resposta: (A) Tecnologia.
 Publicado em 2025-04-30 16:45:17 por #Unicamp [1052 hits]
Publicado em 2025-04-30 16:45:17 por #Unicamp [1052 hits](A) Tecnologia. (B) Alimentação. (C) Vestuário. (D) Transporte.
Resposta: (A) Tecnologia.
57: QUAL PERCENTUAL DA POPULAÇÃO TEM HIPERTENSÃO?
 Publicado em 2025-04-25 11:45:11 por #Unicamp [432 hits]
Publicado em 2025-04-25 11:45:11 por #Unicamp [432 hits]
(A) 25%. (B) 35%. (C) 45%. (D) 55%.
Resposta: (B) 35%.
 Publicado em 2025-04-25 11:45:11 por #Unicamp [432 hits]
Publicado em 2025-04-25 11:45:11 por #Unicamp [432 hits](A) 25%. (B) 35%. (C) 45%. (D) 55%.
Resposta: (B) 35%.
58: QUAL ESCORPIÃO É MAIS PERIGOSO?
 Publicado em 2025-04-24 18:45:25 por #Unicamp [369 hits]
Publicado em 2025-04-24 18:45:25 por #Unicamp [369 hits]
(A) Preto. (B) Amarelo. (C) Marrom. (D) Branco.
Resposta: (B) Amarelo.
 Publicado em 2025-04-24 18:45:25 por #Unicamp [369 hits]
Publicado em 2025-04-24 18:45:25 por #Unicamp [369 hits](A) Preto. (B) Amarelo. (C) Marrom. (D) Branco.
Resposta: (B) Amarelo.
59: O QUE COMPROMETE ÍNDICES GLICÊMICOS?
 Publicado em 2025-04-22 12:45:26 por #Unicamp [355 hits]
Publicado em 2025-04-22 12:45:26 por #Unicamp [355 hits]
(A) Proteínas. (B) Gorduras. (C) Vitaminas. (D) Minerais.
Resposta: (B) Gorduras.
 Publicado em 2025-04-22 12:45:26 por #Unicamp [355 hits]
Publicado em 2025-04-22 12:45:26 por #Unicamp [355 hits](A) Proteínas. (B) Gorduras. (C) Vitaminas. (D) Minerais.
Resposta: (B) Gorduras.
60: O QUE A CASCA DA JABUTICABA AJUDA A CONTROLAR?
 Publicado em 2025-04-17 18:45:23 por #Unicamp [418 hits]
Publicado em 2025-04-17 18:45:23 por #Unicamp [418 hits]
(A) Hiperglicemia. (B) Febre. (C) Dor. (D) Insônia.
Resposta: (A) Hiperglicemia.
 Publicado em 2025-04-17 18:45:23 por #Unicamp [418 hits]
Publicado em 2025-04-17 18:45:23 por #Unicamp [418 hits](A) Hiperglicemia. (B) Febre. (C) Dor. (D) Insônia.
Resposta: (A) Hiperglicemia.
61: ONDE SE ENCONTRAM AFLATOXINAS?
 Publicado em 2025-04-14 18:45:30 por #Unicamp [384 hits]
Publicado em 2025-04-14 18:45:30 por #Unicamp [384 hits]
(A) Carnes. (B) Amendoim. (C) Leite. (D) Frutas.
Resposta: (B) Amendoim.
 Publicado em 2025-04-14 18:45:30 por #Unicamp [384 hits]
Publicado em 2025-04-14 18:45:30 por #Unicamp [384 hits](A) Carnes. (B) Amendoim. (C) Leite. (D) Frutas.
Resposta: (B) Amendoim.
62: ONDE O "TERRORISMO NUTRICIONAL" GANHA MAIS FORÇA?
 Publicado em 2025-03-27 19:45:06 por #Unicamp [382 hits]
Publicado em 2025-03-27 19:45:06 por #Unicamp [382 hits]
(A) Jornais impressos. (B) Programas de rádio. (C) Redes sociais. (D) Livros técnicos.
Resposta: (C) Redes sociais.
 Publicado em 2025-03-27 19:45:06 por #Unicamp [382 hits]
Publicado em 2025-03-27 19:45:06 por #Unicamp [382 hits](A) Jornais impressos. (B) Programas de rádio. (C) Redes sociais. (D) Livros técnicos.
Resposta: (C) Redes sociais.
63: O QUE AFASTA AS PESSOAS DE TOMAR LEITE?
 Publicado em 2025-03-24 13:45:11 por #Unicamp [401 hits]
Publicado em 2025-03-24 13:45:11 por #Unicamp [401 hits]
(A) Sabor. (B) Desinformação. (C) Preço. (D) Disponibilidade.
Resposta: (B) Desinformação.
 Publicado em 2025-03-24 13:45:11 por #Unicamp [401 hits]
Publicado em 2025-03-24 13:45:11 por #Unicamp [401 hits](A) Sabor. (B) Desinformação. (C) Preço. (D) Disponibilidade.
Resposta: (B) Desinformação.
64: QUEM DEVE EVITAR O GLÚTEN?
 Publicado em 2025-03-17 12:45:17 por #Unicamp [110078 hits]
Publicado em 2025-03-17 12:45:17 por #Unicamp [110078 hits]
(A) Diabéticos. (B) Celíacos. (C) Hipertensos. (D) Asmáticos.
Resposta: (B) Celíacos.
 Publicado em 2025-03-17 12:45:17 por #Unicamp [110078 hits]
Publicado em 2025-03-17 12:45:17 por #Unicamp [110078 hits](A) Diabéticos. (B) Celíacos. (C) Hipertensos. (D) Asmáticos.
Resposta: (B) Celíacos.
65: QUAL É O PROBLEMA DE SUBSTITUIR O ARROZ?
 Publicado em 2025-03-10 13:45:07 por #Unicamp [396 hits]
Publicado em 2025-03-10 13:45:07 por #Unicamp [396 hits]
(A) Aumenta o valor nutricional. (B) Enfraquece o valor nutricional. (C) Melhora o sabor das refeições. (D) Reduz o custo das refeições.
Resposta: (B) Enfraquece o valor nutricional.
 Publicado em 2025-03-10 13:45:07 por #Unicamp [396 hits]
Publicado em 2025-03-10 13:45:07 por #Unicamp [396 hits](A) Aumenta o valor nutricional. (B) Enfraquece o valor nutricional. (C) Melhora o sabor das refeições. (D) Reduz o custo das refeições.
Resposta: (B) Enfraquece o valor nutricional.
66: POR QUE OS MACACOS SÃO IMPORTANTES NO MONITORAMENTO DA FEBRE AMARELA?
 Publicado em 2025-03-05 04:45:05 por #Unicamp [404 hits]
Publicado em 2025-03-05 04:45:05 por #Unicamp [404 hits]
(A) Eles transmitem a doença. (B) Eles sinalizam áreas de risco. (C) Eles combatem os mosquitos. (D) Eles vacinam humanos.
Resposta: (B) Eles sinalizam áreas de risco.
 Publicado em 2025-03-05 04:45:05 por #Unicamp [404 hits]
Publicado em 2025-03-05 04:45:05 por #Unicamp [404 hits](A) Eles transmitem a doença. (B) Eles sinalizam áreas de risco. (C) Eles combatem os mosquitos. (D) Eles vacinam humanos.
Resposta: (B) Eles sinalizam áreas de risco.
67: QUAL É O RISCO DE COLISÃO DO ASTEROIDE 2024 YR4 COM A TERRA?
 Publicado em 2025-02-20 10:45:08 por #Unicamp [426 hits]
Publicado em 2025-02-20 10:45:08 por #Unicamp [426 hits]
(A) 1%. (B) 2,3%. (C) 5%. (D) 10%.
Veja a resposta no WhatsApp ou Telegram e compartilhe este Quiz Agrosoft.
 Publicado em 2025-02-20 10:45:08 por #Unicamp [426 hits]
Publicado em 2025-02-20 10:45:08 por #Unicamp [426 hits](A) 1%. (B) 2,3%. (C) 5%. (D) 10%.
Veja a resposta no WhatsApp ou Telegram e compartilhe este Quiz Agrosoft.
68: IMPACTOS DA GUERRA COMERCIAL DE TRUMP
 Publicado em 2025-02-14 18:45:06 por #Unicamp [363 hits]
Publicado em 2025-02-14 18:45:06 por #Unicamp [363 hits]
O presidente dos Estados Unidos, Donald Trump, desencadeou uma guerra tarifária com a China, o México e o Canadá, os três principais parceiros comerciais dos norte-americanos.
 Publicado em 2025-02-14 18:45:06 por #Unicamp [363 hits]
Publicado em 2025-02-14 18:45:06 por #Unicamp [363 hits]O presidente dos Estados Unidos, Donald Trump, desencadeou uma guerra tarifária com a China, o México e o Canadá, os três principais parceiros comerciais dos norte-americanos.
69: CIRCULAÇÃO SIMULTÂNEA AUMENTA GRAVIDADE DA DENGUE
 Publicado em 2025-02-06 15:45:04 por #Unicamp [326 hits]
Publicado em 2025-02-06 15:45:04 por #Unicamp [326 hits]
A circulação simultânea de mais de um sorotipo do vírus da dengue pode aumentar o risco de reinfecção e agravar o quadro da doença na população.
 Publicado em 2025-02-06 15:45:04 por #Unicamp [326 hits]
Publicado em 2025-02-06 15:45:04 por #Unicamp [326 hits]A circulação simultânea de mais de um sorotipo do vírus da dengue pode aumentar o risco de reinfecção e agravar o quadro da doença na população.
70: POR QUE O PREÇO DOS ALIMENTOS SUBIU TANTO?
 Publicado em 2025-01-28 18:45:14 por #Unicamp [403 hits]
Publicado em 2025-01-28 18:45:14 por #Unicamp [403 hits]
As carnes, o café, o leite e a laranja estão entre os alimentos que mais impactaram o orçamento da população em 2024, segundo o Índice Nacional de Preços ao Consumidor Amplo (IPCA).
 Publicado em 2025-01-28 18:45:14 por #Unicamp [403 hits]
Publicado em 2025-01-28 18:45:14 por #Unicamp [403 hits]As carnes, o café, o leite e a laranja estão entre os alimentos que mais impactaram o orçamento da população em 2024, segundo o Índice Nacional de Preços ao Consumidor Amplo (IPCA).
71: COMO LIDAR COM A ANSIEDADE E O ESTRESSE NO TRABALHO?
 Publicado em 2025-01-22 18:45:13 por #Unicamp [330 hits]
Publicado em 2025-01-22 18:45:13 por #Unicamp [330 hits]
Com a chegada do “Janeiro Branco”, a Unicamp destaca a importância do autocuidado para prevenir o agravamento de sintomas como ansiedade e estresse.
 Publicado em 2025-01-22 18:45:13 por #Unicamp [330 hits]
Publicado em 2025-01-22 18:45:13 por #Unicamp [330 hits]Com a chegada do “Janeiro Branco”, a Unicamp destaca a importância do autocuidado para prevenir o agravamento de sintomas como ansiedade e estresse.
72: O DESAFIO DO TAMANHO DE UMA FLORESTA
 Publicado em 2025-01-20 05:45:39 por #Unicamp [408 hits]
Publicado em 2025-01-20 05:45:39 por #Unicamp [408 hits]
Uma competição internacional, uma equipe brasileira e um horizonte de desafios para pesquisadores do Instituto de Biologia da Unicamp (IB) na floresta Amazônica.
 Publicado em 2025-01-20 05:45:39 por #Unicamp [408 hits]
Publicado em 2025-01-20 05:45:39 por #Unicamp [408 hits]Uma competição internacional, uma equipe brasileira e um horizonte de desafios para pesquisadores do Instituto de Biologia da Unicamp (IB) na floresta Amazônica.
73: PAÍSES VIZINHOS PAGAM MENOS IMPOSTOS, MAS NÃO TÊM SUS
 Publicado em 2025-01-02 15:45:03 por #Unicamp [438 hits]
Publicado em 2025-01-02 15:45:03 por #Unicamp [438 hits]
Francisco Luiz Lopreato, professor do Instituto de Economia (IE) da Unicamp, aborda uma questão crucial: por que o Brasil tem uma carga tributária tão alta em comparação a países vizinhos?
 Publicado em 2025-01-02 15:45:03 por #Unicamp [438 hits]
Publicado em 2025-01-02 15:45:03 por #Unicamp [438 hits]Francisco Luiz Lopreato, professor do Instituto de Economia (IE) da Unicamp, aborda uma questão crucial: por que o Brasil tem uma carga tributária tão alta em comparação a países vizinhos?
74: PESQUISA INVESTIGA IMPACTO DAS MUDANÇAS CLIMÁTICAS NA MATA ATLÂNTICA
 Publicado em 2024-12-23 04:45:37 por #Unicamp [452 hits]
Publicado em 2024-12-23 04:45:37 por #Unicamp [452 hits]
Uma rede de pesquisadores brasileiros foi formada com o objetivo de reunir estudos que relacionam a Mata Atlântica às mudanças climáticas.
 Publicado em 2024-12-23 04:45:37 por #Unicamp [452 hits]
Publicado em 2024-12-23 04:45:37 por #Unicamp [452 hits]Uma rede de pesquisadores brasileiros foi formada com o objetivo de reunir estudos que relacionam a Mata Atlântica às mudanças climáticas.
75: RADAR METEOROLÓGICO REVELA PRIMEIRAS IMAGENS DE EVENTOS CLIMÁTICOS
 Publicado em 2024-12-13 16:45:05 por #Unicamp [400 hits]
Publicado em 2024-12-13 16:45:05 por #Unicamp [400 hits]
Entrou em operação no Centro de Pesquisas Meteorológicas Aplicadas à Agricultura da Unicamp o mais moderno radar meteorológico do país, capaz de identificar eventos climáticos extremos.
 Publicado em 2024-12-13 16:45:05 por #Unicamp [400 hits]
Publicado em 2024-12-13 16:45:05 por #Unicamp [400 hits]Entrou em operação no Centro de Pesquisas Meteorológicas Aplicadas à Agricultura da Unicamp o mais moderno radar meteorológico do país, capaz de identificar eventos climáticos extremos.
76: IMAGENS DE SATÉLITE PARA MONITORAR SAÚDE DE MANGUEZAIS
 Publicado em 2024-12-12 04:45:19 por #Unicamp [469 hits]
Publicado em 2024-12-12 04:45:19 por #Unicamp [469 hits]
Uma pesquisa desenvolvida junto ao Instituto de Geociências (IG) da Unicamp criou uma metodologia capaz de analisar a saúde dos manguezais atingidos por derramamentos de petróleo.
 Publicado em 2024-12-12 04:45:19 por #Unicamp [469 hits]
Publicado em 2024-12-12 04:45:19 por #Unicamp [469 hits]Uma pesquisa desenvolvida junto ao Instituto de Geociências (IG) da Unicamp criou uma metodologia capaz de analisar a saúde dos manguezais atingidos por derramamentos de petróleo.
77: O QUE ESTÁ POR TRÁS DA CRISE DA CARNE BRASILEIRA
 Publicado em 2024-11-28 09:45:41 por #Unicamp [417 hits]
Publicado em 2024-11-28 09:45:41 por #Unicamp [417 hits]
Depois que Carrefour decidiu suspender a compra de carne do mercado brasileiro, frigoríficos brasileiros resolveram interromper o fornecimento às lojas do hipermercado no Brasil.
 Publicado em 2024-11-28 09:45:41 por #Unicamp [417 hits]
Publicado em 2024-11-28 09:45:41 por #Unicamp [417 hits]Depois que Carrefour decidiu suspender a compra de carne do mercado brasileiro, frigoríficos brasileiros resolveram interromper o fornecimento às lojas do hipermercado no Brasil.
78: PATAMAR POSITIVO NÃO SIGNIFICA PLENO EMPREGO
 Publicado em 2024-11-27 18:45:12 por #Unicamp [355 hits]
Publicado em 2024-11-27 18:45:12 por #Unicamp [355 hits]
O pleno emprego seria o momento no qual todas as pessoas que procuram um trabalho no país conseguem desempenhar uma atividade remunerada.
 Publicado em 2024-11-27 18:45:12 por #Unicamp [355 hits]
Publicado em 2024-11-27 18:45:12 por #Unicamp [355 hits]O pleno emprego seria o momento no qual todas as pessoas que procuram um trabalho no país conseguem desempenhar uma atividade remunerada.
79: PEC QUE ALTERA JORNADA 6X1 LEVANTA DISCUSSÃO SOBRE TEMPO DEDICADO AO TRABALHO
 Publicado em 2024-11-19 17:45:06 por #Unicamp [380 hits]
Publicado em 2024-11-19 17:45:06 por #Unicamp [380 hits]
A Proposta de Emenda Constitucional (PEC) que altera a jornada de trabalho no Brasil recebeu o número suficiente de assinaturas para entrar em tramitação no Congresso Nacional.
 Publicado em 2024-11-19 17:45:06 por #Unicamp [380 hits]
Publicado em 2024-11-19 17:45:06 por #Unicamp [380 hits]A Proposta de Emenda Constitucional (PEC) que altera a jornada de trabalho no Brasil recebeu o número suficiente de assinaturas para entrar em tramitação no Congresso Nacional.
80: O QUE É E QUAIS AGENTES ATUAM NO MERCADO FINANCEIRO?
 Publicado em 2024-11-13 16:45:02 por #Unicamp [385 hits]
Publicado em 2024-11-13 16:45:02 por #Unicamp [385 hits]
O mercado financeiro é o ambiente que possibilita a negociação de recursos entre diversos agentes econômicos. Existem, basicamente, cinco tipos de mercados que compõem o mercado financeiro.
 Publicado em 2024-11-13 16:45:02 por #Unicamp [385 hits]
Publicado em 2024-11-13 16:45:02 por #Unicamp [385 hits]O mercado financeiro é o ambiente que possibilita a negociação de recursos entre diversos agentes econômicos. Existem, basicamente, cinco tipos de mercados que compõem o mercado financeiro.
81: PRESSÃO DE 12 POR 7 É PRESSÃO ALTA?
 Publicado em 2024-11-08 15:45:02 por #Unicamp [400 hits]
Publicado em 2024-11-08 15:45:02 por #Unicamp [400 hits]
O cardiologista Wilson N. Júnior, professor de cardiologia da Unicamp, explica qual a mudança no diagnóstico de hipertensão arterial e tranquiliza as pessoas que se surpreenderam com as informações.
 Publicado em 2024-11-08 15:45:02 por #Unicamp [400 hits]
Publicado em 2024-11-08 15:45:02 por #Unicamp [400 hits]O cardiologista Wilson N. Júnior, professor de cardiologia da Unicamp, explica qual a mudança no diagnóstico de hipertensão arterial e tranquiliza as pessoas que se surpreenderam com as informações.
82: GUIA ALIMENTAR PARA VEGETARIANOS
 Publicado em 2024-10-28 18:45:02 por #Unicamp [362 hits]
Publicado em 2024-10-28 18:45:02 por #Unicamp [362 hits]
A nutricionista Tatiana Consoli Nannetti Dias desenvolveu um guia alimentar para vegetarianos estritos utilizando alimentos normalmente consumidos no Brasil.
 Publicado em 2024-10-28 18:45:02 por #Unicamp [362 hits]
Publicado em 2024-10-28 18:45:02 por #Unicamp [362 hits]A nutricionista Tatiana Consoli Nannetti Dias desenvolveu um guia alimentar para vegetarianos estritos utilizando alimentos normalmente consumidos no Brasil.
83: MAPEAMENTO DESVENDOU TIPO SANGUÍNEO RARO
 Publicado em 2024-10-17 16:45:05 por #Unicamp [421 hits]
Publicado em 2024-10-17 16:45:05 por #Unicamp [421 hits]
Pesquisadores da Universidade de Bristol, no Reino Unido, desvendaram por completo um novo sistema de grupo sanguíneo. É um tipo raríssimo, presente em 0,01% da população mundial.
 Publicado em 2024-10-17 16:45:05 por #Unicamp [421 hits]
Publicado em 2024-10-17 16:45:05 por #Unicamp [421 hits]Pesquisadores da Universidade de Bristol, no Reino Unido, desvendaram por completo um novo sistema de grupo sanguíneo. É um tipo raríssimo, presente em 0,01% da população mundial.
84: ARTRITE REUMATOIDE E FIBROMIALGIA: DESAFIOS E CUIDADOS
 Publicado em 2024-10-14 14:45:02 por #Unicamp [394 hits]
Publicado em 2024-10-14 14:45:02 por #Unicamp [394 hits]
O podcast Ressonância aborda duas doenças reumatológicas: artrite reumatoide e fibromialgia. O entrevistado é o médico reumatologista do Hospital de Clínicas (HC) da Unicamp Manoel Barros Bertolo.
 Publicado em 2024-10-14 14:45:02 por #Unicamp [394 hits]
Publicado em 2024-10-14 14:45:02 por #Unicamp [394 hits]O podcast Ressonância aborda duas doenças reumatológicas: artrite reumatoide e fibromialgia. O entrevistado é o médico reumatologista do Hospital de Clínicas (HC) da Unicamp Manoel Barros Bertolo.
85: DISPOSITIVO DETECTA SINAL DE INFARTO PELA SALIVA
 Publicado em 2024-10-11 15:45:04 por #Record [439 hits]
Publicado em 2024-10-11 15:45:04 por #Record [439 hits]
Pesquisadores da Unicamp desenvolveram dispositivos capazes de detectar diversas doenças, como o infarto, sem a necessidade de exames laboratoriais, a partir da saliva do paciente.
 Publicado em 2024-10-11 15:45:04 por #Record [439 hits]
Publicado em 2024-10-11 15:45:04 por #Record [439 hits]Pesquisadores da Unicamp desenvolveram dispositivos capazes de detectar diversas doenças, como o infarto, sem a necessidade de exames laboratoriais, a partir da saliva do paciente.
86: O PERCURSO CIENTÍFICO PARA MEDIR A VELOCIDADE DA LUZ
 Publicado em 2024-10-02 16:45:01 por #Unicamp [401 hits]
Publicado em 2024-10-02 16:45:01 por #Unicamp [401 hits]
O físico e professor da Unicamp Peter Schulz fala sobre a velocidade da luz e o percurso de diversos cientistas, ao longo da história, para chegar à medida próxima a 300.000 km/s.
 Publicado em 2024-10-02 16:45:01 por #Unicamp [401 hits]
Publicado em 2024-10-02 16:45:01 por #Unicamp [401 hits]O físico e professor da Unicamp Peter Schulz fala sobre a velocidade da luz e o percurso de diversos cientistas, ao longo da história, para chegar à medida próxima a 300.000 km/s.
87: O QUE REPRESENTA A DESCOBERTA DE GRAFENO NA LUA?
 Publicado em 2024-09-27 17:45:03 por #Unicamp [542 hits]
Publicado em 2024-09-27 17:45:03 por #Unicamp [542 hits]
Pesquisadores da Academia Chinesa de Ciências relataram a descoberta de camadas finas de grafeno na lua.
 Publicado em 2024-09-27 17:45:03 por #Unicamp [542 hits]
Publicado em 2024-09-27 17:45:03 por #Unicamp [542 hits]Pesquisadores da Academia Chinesa de Ciências relataram a descoberta de camadas finas de grafeno na lua.
88: CERRADO ESTÁ SECANDO: HÁ RISCO DE FALTAR ÁGUA?
 Publicado em 2024-09-25 15:45:05 por #SBT [429 hits]
Publicado em 2024-09-25 15:45:05 por #SBT [429 hits]
O especialista em cerrado, doutor em Ecologia pela Unicamp e professor de biologia da UFMG José Eugênio Figueira fala sobre as queimadas no Cerrado, que aumentaram 221% em agosto de 2024.
 Publicado em 2024-09-25 15:45:05 por #SBT [429 hits]
Publicado em 2024-09-25 15:45:05 por #SBT [429 hits]O especialista em cerrado, doutor em Ecologia pela Unicamp e professor de biologia da UFMG José Eugênio Figueira fala sobre as queimadas no Cerrado, que aumentaram 221% em agosto de 2024.
89: POR QUE OS VÍRUS EMERGENTES SE TORNARAM UM DESAFIO DE SAÚDE GLOBAL?
 Publicado em 2024-09-06 15:45:03 por #Unicamp [411 hits]
Publicado em 2024-09-06 15:45:03 por #Unicamp [411 hits]
Os vírus emergentes têm se tornado um desafio de saúde pública global. O professor José Luiz Módena, da Unicamp, explica que as doenças causadas por vírus emergentes são aquelas desconhecidas.
 Publicado em 2024-09-06 15:45:03 por #Unicamp [411 hits]
Publicado em 2024-09-06 15:45:03 por #Unicamp [411 hits]Os vírus emergentes têm se tornado um desafio de saúde pública global. O professor José Luiz Módena, da Unicamp, explica que as doenças causadas por vírus emergentes são aquelas desconhecidas.
90: INCÊNDIOS TRANSFORMAM RIOS VOADORES EM RIOS DE FUMAÇA
 Publicado em 2024-08-28 17:45:06 por #Unicamp [382 hits]
Publicado em 2024-08-28 17:45:06 por #Unicamp [382 hits]
O professor emérito da Unicamp Carlos Alfredo Joly aponta a degradação ambiental como um dos fatores que contribuíram para a propagação do fogo em cidades como Ribeirão Preto.
 Publicado em 2024-08-28 17:45:06 por #Unicamp [382 hits]
Publicado em 2024-08-28 17:45:06 por #Unicamp [382 hits]O professor emérito da Unicamp Carlos Alfredo Joly aponta a degradação ambiental como um dos fatores que contribuíram para a propagação do fogo em cidades como Ribeirão Preto.
91: PERSEGUIDA POR DENUNCIAR AGROTÓXICOS
 Publicado em 2024-08-23 11:45:04 por #Unicamp [593 hits]
Publicado em 2024-08-23 11:45:04 por #Unicamp [593 hits]
As ameaças à pesquisadora Larissa Mies Bombardi, professora da USP, ocorreram após a publicação do atlas Uma geografia do uso de agrotóxicos no Brasil e suas relações com a União Europeia.
 Publicado em 2024-08-23 11:45:04 por #Unicamp [593 hits]
Publicado em 2024-08-23 11:45:04 por #Unicamp [593 hits]As ameaças à pesquisadora Larissa Mies Bombardi, professora da USP, ocorreram após a publicação do atlas Uma geografia do uso de agrotóxicos no Brasil e suas relações com a União Europeia.
92: OXIGÊNIO ESCURO: POR QUE ELE PODE MUDAR A COMPREENSÃO SOBRE A ORIGEM DA VIDA
 Publicado em 2024-08-15 18:45:06 por #Unicamp [431 hits]
Publicado em 2024-08-15 18:45:06 por #Unicamp [431 hits]
Um grupo de cientistas de diferentes países descobriu haver produção de oxigênio no fundo do Oceano Pacífico, onde não há luz. A descoberta identificou uma fonte de oxigênio diferente da fotossíntese.
 Publicado em 2024-08-15 18:45:06 por #Unicamp [431 hits]
Publicado em 2024-08-15 18:45:06 por #Unicamp [431 hits]Um grupo de cientistas de diferentes países descobriu haver produção de oxigênio no fundo do Oceano Pacífico, onde não há luz. A descoberta identificou uma fonte de oxigênio diferente da fotossíntese.
93: NOVO OROPOUCHE É CAPAZ DE SE REPLICAR 100 VEZES MAIS QUE O ORIGINAL
 Publicado em 2024-08-13 17:45:05 por #Unicamp [415 hits]
Publicado em 2024-08-13 17:45:05 por #Unicamp [415 hits]
Um vírus potente, se replica mais e melhor, infectando as pessoas que já tiveram a doença. Esta é a nova variante do vírus responsável pela febre do oropouche, doença com sintomas similares à dengue.
 Publicado em 2024-08-13 17:45:05 por #Unicamp [415 hits]
Publicado em 2024-08-13 17:45:05 por #Unicamp [415 hits]Um vírus potente, se replica mais e melhor, infectando as pessoas que já tiveram a doença. Esta é a nova variante do vírus responsável pela febre do oropouche, doença com sintomas similares à dengue.
94: IDENTIFICADA LIGAÇÃO ENTRE COVID-19 E ACELERAÇÃO DO ENVELHECIMENTO DO CÉREBRO
 Publicado em 2024-07-30 15:45:03 por #TVCultura [473 hits]
Publicado em 2024-07-30 15:45:03 por #TVCultura [473 hits]
Uma pesquisa recentemente publicada da Unicamp descobriu que a Covid-19 pode afetar o cérebro de maneira semelhante ao Alzheimer e à esquizofrenia.
 Publicado em 2024-07-30 15:45:03 por #TVCultura [473 hits]
Publicado em 2024-07-30 15:45:03 por #TVCultura [473 hits]Uma pesquisa recentemente publicada da Unicamp descobriu que a Covid-19 pode afetar o cérebro de maneira semelhante ao Alzheimer e à esquizofrenia.
95: OS CUSTOS FINANCEIROS E SOCIAIS DA GRAVIDEZ NÃO PLANEJADA
 Publicado em 2024-06-18 13:00:02 por #FAPESP [483 hits]
Publicado em 2024-06-18 13:00:02 por #FAPESP [483 hits]
Médico Luis Bahamondes, professor emérito da Unicamp, defende a criação de políticas públicas de atendimento à saúde da mulher no Brasil.
 Publicado em 2024-06-18 13:00:02 por #FAPESP [483 hits]
Publicado em 2024-06-18 13:00:02 por #FAPESP [483 hits]Médico Luis Bahamondes, professor emérito da Unicamp, defende a criação de políticas públicas de atendimento à saúde da mulher no Brasil.
96: ESTUDO DA UNICAMP REVELA POTENCIAL DA CASCA DA FRUTA
 Publicado em 2024-05-29 09:00:03 por #AgroMais [503 hits]
Publicado em 2024-05-29 09:00:03 por #AgroMais [503 hits]
No programa Frutas S.A. desta semana, Simone Garcia convida Mário Maróstica, engenheiro de alimentos da Universidade Estadual de Campinas (Unicamp), para falar sobre os benefícios da jabuticaba.
 Publicado em 2024-05-29 09:00:03 por #AgroMais [503 hits]
Publicado em 2024-05-29 09:00:03 por #AgroMais [503 hits]No programa Frutas S.A. desta semana, Simone Garcia convida Mário Maróstica, engenheiro de alimentos da Universidade Estadual de Campinas (Unicamp), para falar sobre os benefícios da jabuticaba.
97: CENTRO CRIADO NA UNICAMP VAI PRODUZIR CÉLULAS A COMBUSTÍVEIS
 Publicado em 2024-02-27 09:30:02 por #AgroMais [514 hits]
Publicado em 2024-02-27 09:30:02 por #AgroMais [514 hits]
Uma pesquisa da Unicamp vai criar um centro multiusuário para manufatura de células a combustível. O professor Gustavo Doubek, afirmou que a iniciativa pode ajudar o agronegócio a ter um papel de liderança quando o assunto é transição energética.
 Publicado em 2024-02-27 09:30:02 por #AgroMais [514 hits]
Publicado em 2024-02-27 09:30:02 por #AgroMais [514 hits]Uma pesquisa da Unicamp vai criar um centro multiusuário para manufatura de células a combustível. O professor Gustavo Doubek, afirmou que a iniciativa pode ajudar o agronegócio a ter um papel de liderança quando o assunto é transição energética.
98: 2024: ANO DA REGULAMENTAÇÃO DO CARBONO NO BRASIL
 Publicado em 2024-01-18 10:00:02 por #AgroMais [635 hits]
Publicado em 2024-01-18 10:00:02 por #AgroMais [635 hits]
Nos últimos meses temos acompanhado o andamento da regulamentação do mercado de carbono no país a partir de um projeto aprovado pela Câmara dos Deputados e que pode ser analisado novamente pelo Senado para que a lei entre em vigor. O engenheiro da Unicamp e CEO da Eccaplan, Fernando Beltrame, falou sobre como a medida pode impactar o setor agropecuário brasileiro.
 Publicado em 2024-01-18 10:00:02 por #AgroMais [635 hits]
Publicado em 2024-01-18 10:00:02 por #AgroMais [635 hits]Nos últimos meses temos acompanhado o andamento da regulamentação do mercado de carbono no país a partir de um projeto aprovado pela Câmara dos Deputados e que pode ser analisado novamente pelo Senado para que a lei entre em vigor. O engenheiro da Unicamp e CEO da Eccaplan, Fernando Beltrame, falou sobre como a medida pode impactar o setor agropecuário brasileiro.
99: DO PROBLEMA À SOLUÇÃO: O PAPEL DOS BIODIGESTORES NA AGROPECUÁRIA
 Publicado em 2023-12-01 08:30:02 por #AgroMais [526 hits]
Publicado em 2023-12-01 08:30:02 por #AgroMais [526 hits]
O Brasil tem um enorme potencial de geração de biogás em toda sua extensão territorial. E pensando em otimizar a produção no estado de São Paulo, a Universidade de Campinas, Unicamp, vem desenvolvendo pesquisas que apontam a destinação mais adequada para os resíduos da pecuária e da indústria de cana.
 Publicado em 2023-12-01 08:30:02 por #AgroMais [526 hits]
Publicado em 2023-12-01 08:30:02 por #AgroMais [526 hits]O Brasil tem um enorme potencial de geração de biogás em toda sua extensão territorial. E pensando em otimizar a produção no estado de São Paulo, a Universidade de Campinas, Unicamp, vem desenvolvendo pesquisas que apontam a destinação mais adequada para os resíduos da pecuária e da indústria de cana.
100: AGAVE É USADO PARA PRODUZIR BIOCOMBUSTÍVEL
 Publicado em 2023-11-27 09:30:01 por #Band [778 hits]
Publicado em 2023-11-27 09:30:01 por #Band [778 hits]
Pesquisadores querem produzir energia limpa a partir do Agave, planta que normalmente é usada na produção de tequila. O estudo é brasileiro, feito na Unicamp.
 Publicado em 2023-11-27 09:30:01 por #Band [778 hits]
Publicado em 2023-11-27 09:30:01 por #Band [778 hits]Pesquisadores querem produzir energia limpa a partir do Agave, planta que normalmente é usada na produção de tequila. O estudo é brasileiro, feito na Unicamp.